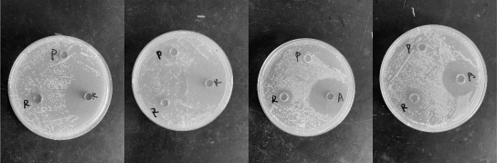

近日,中國水產科學研究院黃海水產研究所海水魚類基因組學及分子育種技術創新團隊在魚類細胞系構建、魚類抗病及生長機制研究等方面取得的5項成果獲國家發明專利授權。
“一種鱘魚胚胎細胞系、培養基及其制備方法”發明專利(專利號ZL 202111399035.3)屬于細胞生物學技術領域,該發明建立的細胞系ADEc株,已于2021年7月28日保藏至中國普通微生物菌種保藏管理中心,保藏號為:CGMCC NO.22360。本發明還提供了一種鱘魚胚胎細胞系培養基,利用該培養基成功獲得第一個鱘魚胚胎細胞系,且連續傳代50代仍保持原代細胞的形態特點,細胞經凍存復蘇后仍能保持高活力。

“一種半滑舌鰨CHST12蛋白及其在抗菌中的應用”發明專利(專利號ZL 202210580670.X)屬于海洋生物技術領域,涉及一種半滑舌鰨CHST12蛋白及其抗菌應用。本發明獲得了半滑舌鰨chst12基因,并發現該基因編碼的半滑舌鰨CHST12蛋白具有抗菌功能,對哈維氏弧菌和遲緩愛德華氏菌均有抗菌效應,不僅為進一步了解半滑舌鰨CHST12蛋白抗菌功能奠定基礎,還為抗菌藥物及殺菌劑的研制提供了基因資源。

“一種篩選抗哈維氏弧菌病半滑舌鰨的標記組合和篩選半滑舌鰨抗病個體的方法”發明專利(專利號ZL 202210706755.8)提供了一種篩選抗哈維氏弧菌病半滑舌鰨的標記組合和篩選半滑舌鰨抗病個體的方法,屬于水產生物技術領域。標記組合包括微生物標記和宿主基因標記:微生物標記包括Alicyclobacillus pohliae、Phaeobacter inhibens和Propionibacterium acnes;宿主基因標記包括soat、meso1等基因。采用本發明提供的標記組合和篩選方法能夠區分抗病和不抗病的半滑舌鰨個體,進而篩選出抗病力強的半滑舌鰨優質良種。

“檢測牙鲆抗病力的引物、重組蛋白及其應用”發明專利(專利號ZL 202111263148.0)公開了一種檢測牙鲆抗病力的引物、重組蛋白并說明了其未來應用方向,該發明屬于分子生物學技術領域,引物序列為SNP?Rnd1?FCAGAGGAACAGCGGAATAGT,SNP?Rnd1?RGCTCCCCAAAAGGTAAGATA。本發明說了該引物在牙鲆抗病品種選育中的應用,可選擇出具有特異性擴增目的片段的個體作為親本,進行牙鲆抗病新品種的選育。基于牙鲆Rnd1基因序列SEQ IP NO.3重組獲得的重組蛋白對金黃葡萄球菌、大腸桿菌、遲緩愛德華氏菌、哈維氏弧菌均具有抑制作用,提供了該重組蛋白在制備防治牙鲆細菌病生物藥品中的應用。
“一種半滑舌鰨miRNA及其在調控tgfb2基因表達中的應用”發明專利(專利號ZL 202210239256.2)涉及一種半滑舌鰨miRNA及其在調控tgfb2基因表達中的應用,屬于分子生物學和基因工程技術領域。該miRNA名稱為novel?m0083?3p,其對應靶基因為半滑舌鰨tgfb2。本發明發現了調控半滑舌鰨tgfb2基因的miRNA,證明利用該miRNA能夠調控tgfb2基因在半滑舌鰨體內的表達,從而調節半滑舌鰨的生長。

主辦單位:黃海水產研究所
魯公網安備: 37020202000458號 魯ICP備:05024434號-8
工信部備案網站查詢:http://beian.miit.gov.cn
網站保留所有權,未經許可不得復制,鏡像